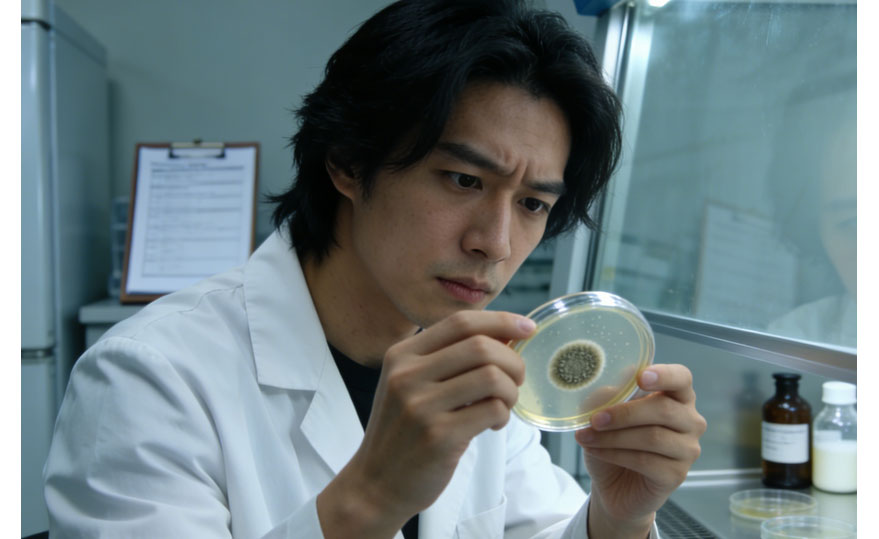

单克隆抗体制备为什么不用浆细胞检测?
单克隆抗体制备过程中并非完全不利用浆细胞的抗体分泌特性,而是不直接以浆细胞作为检测和筛选的核心靶标,核心原因是浆细胞的自身生物学特性、单克隆抗体制备的实验逻辑,以及检测技术的可行性限制,让直接检测浆细胞的操作既不高效也无实际必要,具体可从这几个关键角度理解:
1、浆细胞的终末分化特性,无法体外长期增殖是核心前提
浆细胞是B细胞受抗原刺激后分化的终末细胞,其核心功能是高效分泌特异性抗体,但失去了体外无限增殖的能力,短时间内就会凋亡。而单克隆抗体制备的核心目标是获得“能无限增殖+持续分泌特异性抗体”的杂交瘤细胞,融合实验的本质就是将浆细胞的抗体分泌能力与骨髓瘤细胞的无限增殖能力结合。此时即便能精准检测出分泌目标抗体的浆细胞,也无法直接利用该浆细胞获得大量单克隆抗体,检测结果无法转化为实验产物,失去了筛选的实际意义。
2、浆细胞的分离与单个检测技术难度大,成本极高
抗原免疫后的动物脾脏/淋巴结中,存在大量不同类型的免疫细胞,其中分泌目标抗体的特异性浆细胞占比极低(多为万分之一甚至更低),且浆细胞无特异性表面标志物可直接区分“分泌目标抗体”和“分泌非特异性抗体”的个体,无法通过流式分选等手段快速纯化。同时,单个浆细胞的抗体分泌量极少,现有技术难以对单个未融合的浆细胞进行高效的抗体特异性检测(如ELISA),要实现单浆细胞检测,需复杂的微流控、单细胞测序等技术,远超常规单克隆抗体制备的实验条件,性价比极低。
3、融合后杂交瘤细胞的检测,已间接筛选出含有效浆细胞融合子的群体
单克隆抗体制备中,脾细胞(含B细胞、未完全分化的浆母细胞、浆细胞等)与骨髓瘤细胞融合后,会形成未融合脾细胞、未融合骨髓瘤细胞、融合杂交瘤细胞三类群体,经HAT选择性培养基筛选后,仅杂交瘤细胞能存活。此时对杂交瘤细胞的上清液进行抗体检测,本质就是间接筛选“成功融合了分泌目标抗体的浆细胞/浆母细胞”的杂交瘤——因为只有融合了具备特异性抗体分泌能力的浆系细胞,杂交瘤才会分泌对应抗体,这种检测方式直接对接实验目标,无需回溯检测原始浆细胞。
4、直接检测浆细胞,无法解决单克隆抗体制备的核心筛选需求
单克隆抗体制备的筛选不仅需要“分泌特异性抗体”,还需要验证细胞能否稳定增殖、稳定分泌抗体,而原始浆细胞本身不具备增殖能力,即便检测出其分泌目标抗体,也无法判断该浆细胞的基因信息能否在融合后与骨髓瘤细胞结合,实现“增殖+分泌”的双重稳定。而杂交瘤细胞的体外培养检测,能同时验证增殖能力和抗体分泌的特异性、稳定性,一次筛选即可满足实验的核心要求,是更直接的筛选逻辑。
5、脾细胞中参与融合的核心是浆母细胞/活化B细胞,而非成熟浆细胞
实际实验中,与骨髓瘤细胞融合效率更高、融合后杂交瘤稳定性更好的,并非完全成熟的终末浆细胞,而是浆母细胞(未成熟浆细胞)和经抗原活化的B淋巴细胞——这类细胞仍保留一定的增殖潜能,与骨髓瘤细胞融合后,更易形成功能稳定的杂交瘤。而成熟浆细胞的融合效率低,且融合后易因终末分化特性导致抗体分泌能力快速丧失,因此即便检测成熟浆细胞,也对后续融合实验的指导意义有限。
单克隆抗体制备的核心是获得兼具抗体分泌和无限增殖的杂交瘤细胞,原始浆细胞因无增殖能力,直接检测无实际利用价值;而融合后通过检测杂交瘤细胞上清的抗体,既间接筛选出了融合了有效浆系细胞的克隆,又能同时验证增殖和分泌的稳定性,是贴合实验目标、技术可行且高效的筛选方式。
随着单细胞技术发展,目前已有单细胞分选结合浆细胞测序的技术,可先筛选出分泌目标抗体的单浆细胞,再通过基因克隆制备重组抗体,这是对浆细胞检测的利用,但这属于重组抗体制备范畴,并非传统的杂交瘤法单克隆抗体制备,二者的实验逻辑完全不同。
最新动态
-
05.27
DAP‑Seq实验如何设置对照、保证重复性与数据可靠性?
-
05.27
DAP‑Seq与ChIP‑Seq、CUT&Tag、ATAC‑Seq的关键区别与适用场景?
-
05.26
定制ELISA试剂盒的灵敏度、特异性、重复性等关键性能如何保证?
-
05.11
怎么通过ChIP-seq结果分析转录因子的结合基序与结合位点分布?
-
04.27
双分子荧光互补(BiFC)与FRET的核心区别是什么?
-
04.27
外泌体研究方案中的样本来源与实验模型如何设计?
-
04.24
细胞迁移及侵袭实验攻略
-
04.24
等温量热滴定曲线出现正负峰的原因是什么?
-
04.23
EMSA实验中,细胞核蛋白提取质量对结果影响极大,如何保证蛋白的完整性与结合活性?
-
04.23
免疫荧光检测中常见的非特异性荧光有哪些原因?如何减少或避免?


